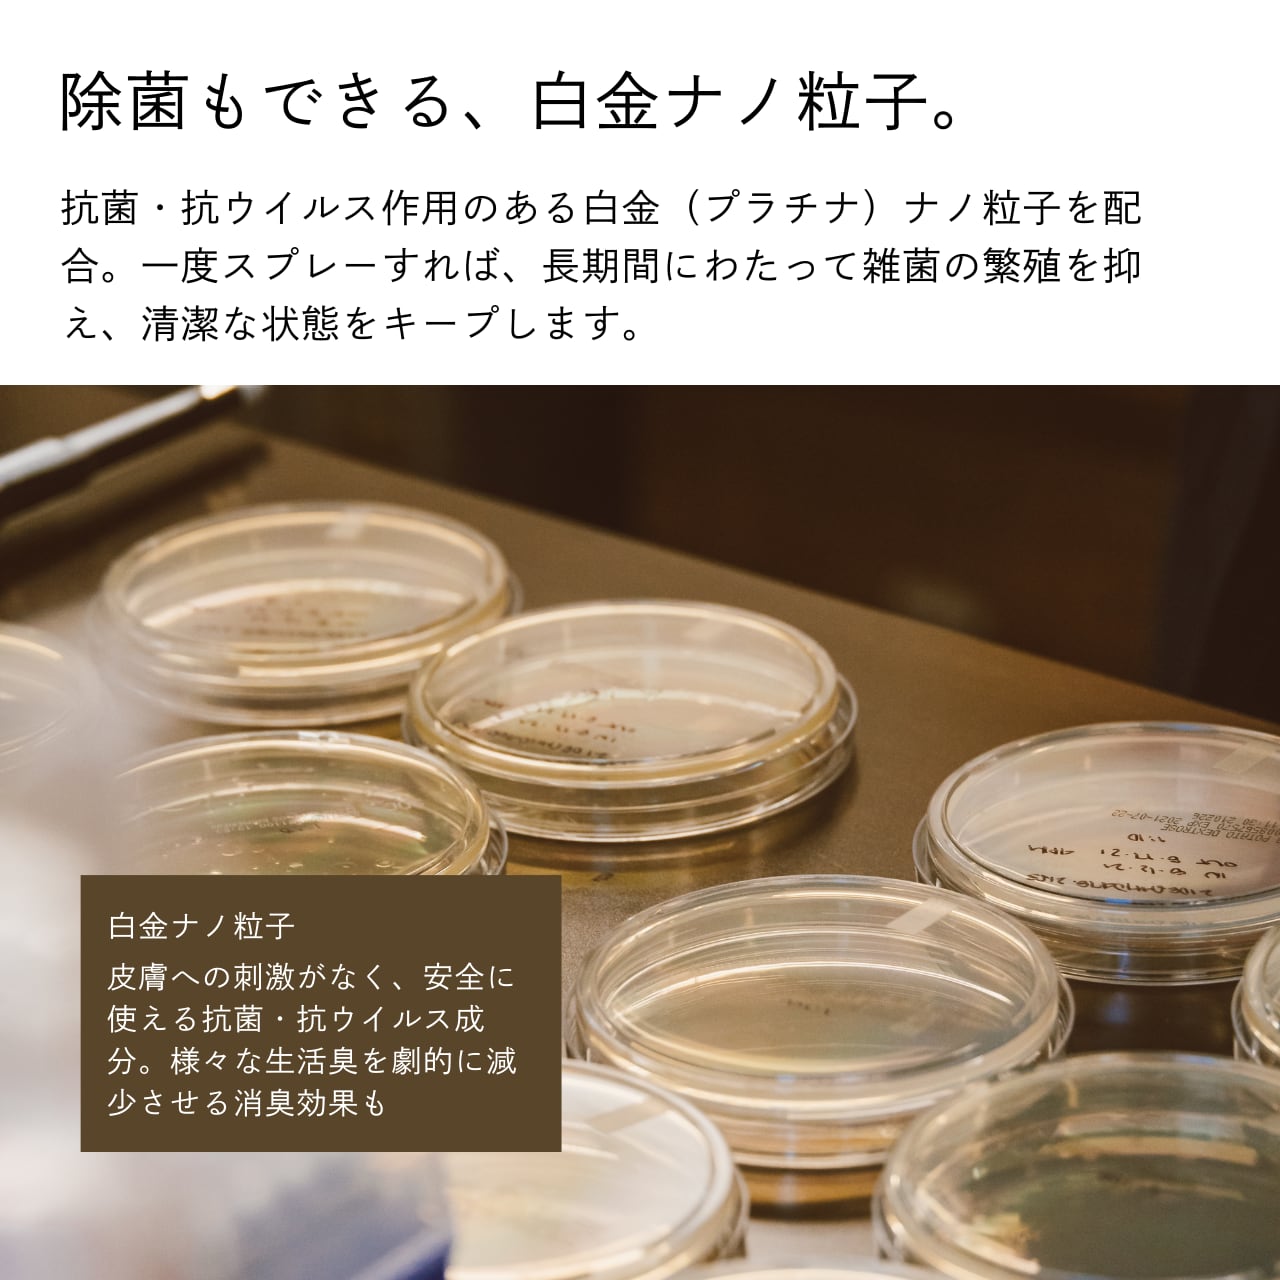

【オリジナルMAP付き】アロマティック ファブリックミスト 3本セット〈数量限定〉
¥5,500 税込
なら 手数料無料で 月々¥1,830から
別途送料がかかります。送料を確認する
この商品は海外配送できる商品です。
服に付いた揚げ物のニオイや、出張先のホテルのニオイ。
衣服や寝具、空間にシュッとスプレーするだけで気になるニオイをリセットし、心地よい香りをふわっと広げるファブリックミストです。
気になるときにいつでも使える、携帯に便利なサイズ感。
外食や飲み会が好きな方、旅行やおでかけが好きな方へのギフトにもおすすめです。
POINT
・天然の消臭成分「カキタンニン」が服に付いた料理のニオイや加齢臭をなかったことに
・抗菌・抗ウイルス効果を持つ「白金ナノ粒子」が長期間にわたって雑菌の繁殖を抑制
・精油のみで調香したナチュラルな香り
・ファブリックミストだけでなく、ルームミストとしても
・美しく高級感のあるフロストガラスのボトル
・エタノール濃度24%未満なので、海外への発送もOK
[香りの特徴]
■TOKYO
フレッシュなミントにマグノリアやコリアンダーの甘さが調和する、カクテルのグラスホッパーを思わせる香り。爽やかで洗練された印象を与えます。
■OSAKA
プチグレンやグレープフルーツのビターなシトラスとウッドを基調とした、甘さのないスッキリとした香り。香りのキレがよく、シーンを問わず使えます。
■FUKUOKA
ブルータンジーやゼラニウム、アグライアを基調にしたグリーンフローラルの香り。オークモスやベルガモットが調和し、潮風のような瑞々しさを感じます。
[使い方]
よく振ってから、20~30cmほど離して衣服や寝具などの布地にスプレーしてください
成分:水、エタノール(24%未満)、界面活性剤、消臭成分、除菌成分、香料
内容量:20mL×3本
原産国:日本
-
送料・配送方法について
-
お支払い方法について
[購入者特典について]
購入者全員に、オリジナルマップをプレゼント!
ガイドブックや口コミサイトには載っていない“いいお宿”と“いいお店”だけを厳選しました。
旅行に、お出かけに、デートに。
どんな時も頼りになる、特別なマップです。